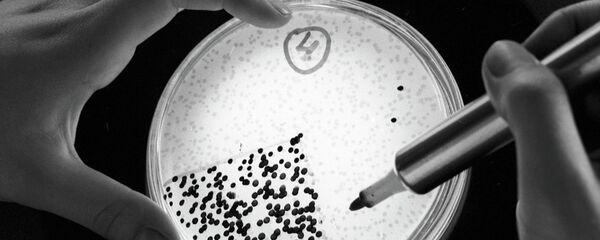
بكتيريا - سبوتنيك عربي

وقالت صحيفة ديلي ميل البريطانية أن علماء من كلية طب ووك فوريست الأمريكية اكتشفوا أن براز الرضع يحتوي على نوع من البكتيريا النافعة يمكنها أن تفيد في علاج العديد من أمراض القناة الهضمية الناتجة عن نقص الدهون قصيرة السلسلة.
وأوضح هاريوم ياديف، المسؤول عن الدراسة، أن الأحماض الدهنية قصيرة السلسلة تعد أحد أهم أسباب تعزيز صحة القناة الهضمية، ويعاني مرضى السكري والسمنة واضطرابات المناعة من نقص كميات هذه الأحماض.
وعمد العلماء إلى استخلاص بكتيريا نافعة من براز الأطفال جمعوها من 34 حفاضة لأطفال أصحاء، وقدموها لفئران التجارب ليتبين لهم أن لها تأثير إيجابي على تحسين صحة القناة الهضمية لديهم.
وأكد ياديف أن هذا الاكتشاف يدل على إمكانية استغلال البكتيريا النافعة المستخلصة من البشر في وضع أنظمة علاجية للأمراض المرتبطة بالميكروبات.